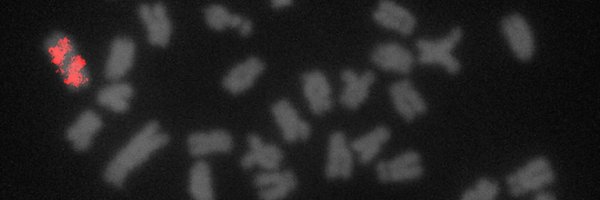
CesarMartins_CM Profile Banner

Cesar Martins
@CesarMartins_CM
Followers
159
Following
58
Media
3
Statuses
53
“In Chromosomes We Trust"
Botucatu, Brazil
Joined February 2019
I am happy to share that our paper "Transcribing the enigma: the B chromosome as a territory of uncharted RNAs" is out in @GeneticsGSA
https://t.co/3cEkTvYR3t
@CesarMartins_CM
@D_CabraldeMello & G Valente #chromosome #genome #evolution #transcriptomics
academic.oup.com
Abstract. B chromosomes are supernumerary elements found in several groups of eukaryotes, including fungi, plants, and animals. Typically, these chromosome
2
10
33
Unesp terá Vestibular Paulista Seriado a partir de 2024! Conselho Universitário da Unesp aprovou a adesão da Universidade a esta nova modalidade de ingresso, que tem como base exame a ser aplicado aos estudantes de ensino médio das escolas estaduais de SP https://t.co/QaIuycb4zU
0
5
19
We are B-yond thrilled that our work on the drive of #BChromosomes in Drosophila melanogaster is officially published in Current Biology! https://t.co/ArDagWkyaX Huge props to Dr. Patrick Ferree for writing a fantastic Dispatch to go along with it! https://t.co/Dt8siBCvky
11
41
132
FINALLY PUBLISHED!!!!!! Integrative Analysis of the Ethanol Tolerance of Saccharomyces cerevisiae https://t.co/Dlb28GeckF
#mdpiijms via @IJMS_MDPI
mdpi.com
Ethanol (EtOH) alters many cellular processes in yeast. An integrated view of different EtOH-tolerant phenotypes and their long noncoding RNAs (lncRNAs) is not yet available. Here, large-scale data...
2
1
1
A Unesp repudia veementemente os atos terroristas e criminosos contra os poderes constituídos do Brasil ocorridos hoje em Brasília. Reafirmamos nossos compromissos com a Democracia e demandamos enfaticamente que os responsáveis sejam punidos. https://t.co/uGVBi0Ltr7
jornal.unesp.br
Leia a manifestação da Reitoria da Unesp.
11
103
619
Excited to share our recent work on "B chromosomes" with the functional genomics and systems biology community at #EMBOOmics
0
1
26
Para marcar a comemoração do Dia das Crianças, a Unesp estreia o quadro "Pílulas de Ciência". A ideia é tirar as dúvidas dos pequenos em vídeos animados sobre diversas questões de como funciona o mundo.
0
3
18
One of PhD chapters it's now published @BMCBiology. We reported piRNA clusters in a genome with the B chromosome, it is a well-resolved genomic conflict story involving transposable elements evolution. @CesarMartins_CM @adautocardoso4
https://t.co/p2pNnHpl5Z
bmcbiol.biomedcentral.com
Background B chromosomes are extra elements found in several eukaryote species. Usually, they do not express a phenotype in the host. However, advances in bioinformatics over the last decades have...
3
4
16
Meiotic behavior, transmission and active genes of B chromosomes in the cichlid Astatotilapia latifasciata: new clues about nature, evolution and maintenance of accessory elements
pubmed.ncbi.nlm.nih.gov
Supernumerary B chromosomes (Bs) are dispensable genetic elements widespread in eukaryotes and are poorly understood mainly in relation to mechanisms of maintenance and transmission. The cichlid...
0
3
6
No artigo publicado no Estadão, reitor Pasqual Barretti enfatiza as ações realizadas durante a pandemia de covid-19: "Jamais paramos de ensinar, de pesquisar, de prestar serviços e de cumprir com a missão como universidade pública". No Portal da Unesp.
2
3
21
Hi all, could you please help circulate that we are offering a three-year postdoctoral position in bioinformatics/computational biology. Salary will be competitive. For those interested, please check out details here: https://t.co/2L4Mza7zmY, or here:
1
182
147
Na perspectiva de retomada plena das atividades presenciais ao longo do ano de 2022, esquema vacinal completo é condição indispensável à frequência nas unidades e nos câmpus da Unesp. Saiba mais no Portal da Unesp
3
22
129
Postdoc position available in my lab! Are you bored of always working with the same models? Join us and let's discover the mysteries of centromere and meiosis adaptations in holocentric plants! RT 🔄 please!
Please RT 🔁 Our own @marques_et_al currently recruits a #postdoc to study meiotic and centromere adaptions in holocentric plants. Key facts are summarised below and more information is available at https://t.co/ZWllKHjsGW
#PlantSciJobs
0
55
68
Fish genomics and its impact on fundamental and applied research of vertebrate biology https://t.co/XuFKqdj2ix
0
4
14
Pesquisadores têm usado as redes sociais para divulgar ciência e fazer uma ponte dela com a sociedade
bbc.com
O objetivo é aproximar a comunidade científica das pessoas e mostrar o valor e a importância da ciência e do conhecimento para a sociedade.
8
41
305
New #openaccess research from @fjruizruano and colleagues: Long-term persistence of supernumerary B #chromosomes in multiple species of #Astyanax fish. #evolution #genomics Read it here: https://t.co/sYVZUG0lrk
1
11
20
GBE latest: Analysis of paralogons, origin of the vertebrate karyotype, and ancient chromosomes retained in extant species
academic.oup.com
Abstract. A manually curated set of ohnolog families has been assembled, for seven species of bony vertebrates, that includes 255 four-member families and
0
5
9
Professora do IB da Unesp Botucatu faz sucesso democratizando a ciência no Tik Tok | Jornal Acontece Botucatu
0
0
0
new leadership and a few new directions for @SpringerNature journal #Chromosome Research: https://t.co/mjz14JAbRk.
@roneilllab #chromatin #genomics
link.springer.com
Chromosome Research -
1
2
25